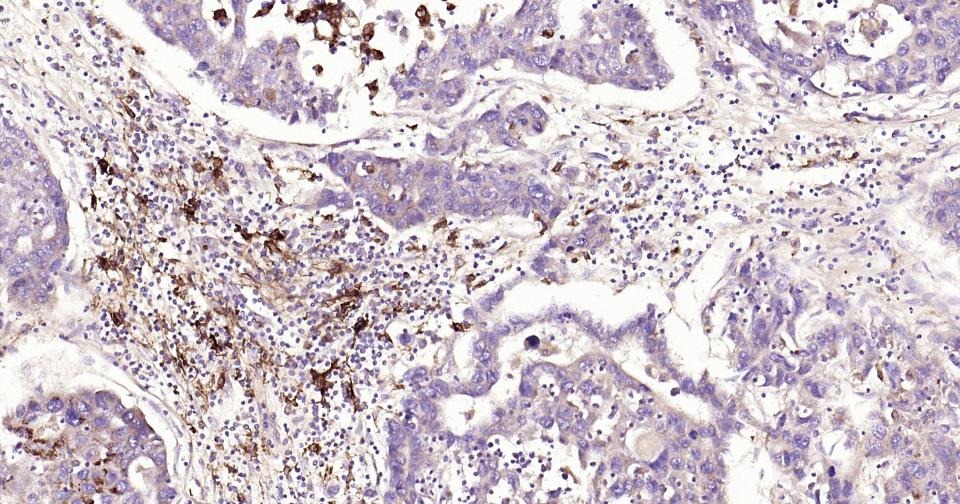
verifiedActivity

购物车
 您的购物车当前为空
您的购物车当前为空
Anti-MMP-9 Antibody (3R987) 是一种 Rabbit 抗体,靶向 MMP-9。Anti-MMP-9 Antibody (3R987) 可用于 IF, IHC-Fr, IHC-P, WB。
别名 MMP-9, MANDP2, GELB, Gelatinase B, CLG4B
Anti-MMP-9 Antibody (3R987) 是一种 Rabbit 抗体,靶向 MMP-9。Anti-MMP-9 Antibody (3R987) 可用于 IF, IHC-Fr, IHC-P, WB。
| 规格 | 价格 | 库存 | 数量 |
|---|---|---|---|
| 25 μL | ¥ 785 | 5日内发货 | |
| 50 μL | ¥ 1,390 | 5日内发货 | |
| 100 μL | ¥ 2,490 | 5日内发货 |
TargetMol的所有产品仅用作科学研究或药证申报,不能被用于人体,我们不向个人提供产品和服务。请您遵守承诺用途,不得违反法律法规规定用于任何其他用途。
| 产品描述 | Anti-MMP-9 Antibody (3R987) is a Rabbit antibody targeting MMP-9. Anti-MMP-9 Antibody (3R987) can be used in IF, IHC-Fr, IHC-P, WB. |
| 别名 | MMP-9, MANDP2, GELB, Gelatinase B, CLG4B |
| Ig Type | IgG |
| 克隆号 | 3R987 |
| 反应种属 | Human,Mouse,Rat |
| 验证活性 | 1. 25 μg total protein per Lane of various lysates probed with MMP9 monoclonal antibody, unconjugated (TMAB-01160) at 1:5000 dilution and 4°C overnight incubation. Followed by conjugated secondary antibody incubation at RT for 60 min. 2. U2OS (H) cells were treated with or without TPA (200nM,48h) for 30 min, 25 μg total protein per Lane of cell lysates probed with MMP9 monoclonal antibody, unconjugated (TMAB-01160) at 1:5000 dilution and 4°C overnight incubation. Followed by conjugated secondary antibody incubation at RT for 60 min. 3. MDA-MB-231 (H) cells were treated with or without TPA (200nM,24h) for 30 min, 25 μg total protein per Lane of cell lysates probed with MMP9 monoclonal antibody, unconjugated (TMAB-01160) at 1:5000 dilution and 4°C overnight incubation. Followed by conjugated secondary antibody incubation at RT for 60 min. 4. Paraformaldehyde-fixed, paraffin embedded Rat Spleen; Antigen retrieval by boiling in sodium citrate buffer (pH6.0) for 15 min; The section was incubated with MMP9 Monoclonal Antibody, Unconjugated (TMAB-01160) at 1:200 overnight at 4°C, followed by conjugation to the SP Kit (Rabbit) and DAB staining. 5. Paraformaldehyde-fixed, paraffin embedded Human Lung Cancer; Antigen retrieval by boiling in sodium citrate buffer (pH6.0) for 15 min; The section was incubated with MMP9 Monoclonal Antibody, Unconjugated (TMAB-01160) at 1:200 overnight at 4°C, followed by conjugation to the SP Kit (Rabbit) and DAB staining. 6. Paraformaldehyde-fixed, paraffin embedded Human Liver Cancer; Antigen retrieval by boiling in sodium citrate buffer (pH6.0) for 15 min; The section was incubated with MMP9 Monoclonal Antibody, Unconjugated (TMAB-01160) at 1:200 overnight at 4°C, followed by conjugation to the SP Kit (Rabbit) and DAB staining. 7. Paraformaldehyde-fixed, paraffin embedded Human Colon Cancer; Antigen retrieval by boiling in sodium citrate buffer (pH6.0) for 15 min; The section was incubated with MMP9 Monoclonal Antibody, Unconjugated (TMAB-01160) at 1:200 overnight at 4°C, followed by conjugation to the SP Kit (Rabbit) and DAB staining. 8. Paraformaldehyde-fixed, paraffin embedded Human Tonsil; Antigen retrieval by boiling in sodium citrate buffer (pH6.0) for 15 min; The section was incubated with MMP9 Monoclonal Antibody, Unconjugated (TMAB-01160) at 1:200 overnight at 4°C, followed by conjugation to the SP Kit (Rabbit) and DAB staining. 9. Paraformaldehyde-fixed, paraffin embedded Mouse Lung; Antigen retrieval by boiling in sodium citrate buffer (pH6.0) for 15 min; The section was incubated with MMP9 Monoclonal Antibody, Unconjugated (TMAB-01160) at 1:200 overnight at 4°C, followed by conjugation to the secondary antibody and DAB staining. 10. Paraformaldehyde-fixed, paraffin embedded Mouse Spleen; Antigen retrieval by boiling in sodium citrate buffer (pH6.0) for 15 min; The section was incubated with MMP9 Monoclonal Antibody, Unconjugated (TMAB-01160) at 1:200 overnight at 4°C, followed by conjugation to the secondary antibody and DAB staining. 11. Paraformaldehyde-fixed, paraffin embedded Human Spleen; Antigen retrieval by boiling in sodium citrate buffer (pH6.0) for 15 min; The section was incubated with MMP9 Monoclonal Antibody, Unconjugated (TMAB-01160) at 1:200 overnight at 4°C, followed by conjugation to the secondary antibody and DAB staining. 12. Paraformaldehyde-fixed, paraffin embedded Human Breast Cancer; Antigen retrieval by boiling in sodium citrate buffer (pH6.0) for 15 min; The section was incubated with MMP9 Monoclonal Antibody, Unconjugated (TMAB-01160) at 1:200 overnight at 4°C, followed by conjugation to the secondary antibody and DAB staining. |
| 应用 | IFIHC-FrIHC-PWB |
| 推荐剂量 | IF=1:200-1000; IHC-Fr=1:200-1000; IHC-P=1:200-1000; WB=1:2000-20000 |
| 抗体种类 | Monoclonal |
| 宿主来源 | Rabbit |
| 亚细胞定位 | Secreted; extracellular space; extracellular matrix. |
| 组织特异性 | Produced by normal alveolar macrophages and granulocytes. Post-translational modifications : Processing of the precursor yields different active forms of 64, 67 and 82 kDa. Sequentially processing by MMP3 yields the 82 kDa matrix metalloproteinase-9. |
| 构建方式 | Recombinant Antibody |
| 纯化方式 | Protein A purified |
| 性状 | Liquid |
| 缓冲液 | 0.01M TBS (pH7.4) with 1% BSA, 0.02% Proclin300 and 50% Glycerol. |
| 浓度 | 1 mg/mL |
| 研究背景 | Proteins of the matrix metalloproteinase (MMP) family are involved in the breakdown of extracellular matrix in normal physiological processes, such as embryonic development, reproduction, and tissue remodeling, as well as in disease processes, such as arthritis and metastasis. Most MMP's are secreted as inactive proproteins which are activated when cleaved by extracellular proteinases. The enzyme encoded by this gene degrades type IV and V collagens. Studies in rhesus monkeys suggest that the enzyme is involved in IL-8-induced mobilization of hematopoietic progenitor cells from bone marrow, and murine studies suggest a role in tumor-associated tissue remodeling. [provided by RefSeq, Jul 2008]. |
| 免疫原 | A synthesized peptide: human MMP9 |
| 抗原种属 | Human |
| 基因名称 | Mmp9 |
| 基因ID | |
| 蛋白名称 | Matrix metalloproteinase-9 |
| Uniprot ID | |
| 研究领域 | MMP,Protease inhibitors ELISA kits,Cancer proteins ELISA kits,Atherosclerotic proteins ELISA kits,MMPs,Thrombosis,MMP,MMPs,MMPs,MMPs |
| 功能 | May play an essential role in local proteolysis of the extracellular matrix and in leukocyte migration. Could play a role in bone osteoclastic resorption. Cleaves KiSS1 at a Gly- -Leu bond. Cleaves type IV and type V collagen into large C-terminal three quarter fragments and shorter N-terminal one quarter fragments. Degrades fibronectin but not laminin or Pz-peptide. |
| 分子量 | Theoretical: 100 kDa. Actual: 85 kDa. |
| 储存方式 | Store at -20°C or -80°C for 12 months. Avoid repeated freeze-thaw cycles. |
| 运输方式 | Shipping with blue ice. |